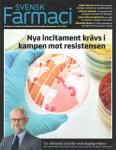
sf-nr-5-2016-493x640

[2016-10-28]
[2016-10-28]
De ökade kraven på lönsamhet som införts efter omregleringen av den svenska apoteksmarknaden har resulterat i en kraftigt försämrad arbetsmiljö som nu börjar synas i sjukskrivningsstatistiken.
Facket på krigsstigen mot dålig arbetsmiljö
Sveriges Farmaceuter kraftsamlar nu för att både kartlägga och åtgärda problemen med dålig arbetsmiljö på apoteken.
Artiklarna publiceras i sin helhet endast i Svensk Farmaci papperstidningen, men en förkortad version kan hittas här >>.




